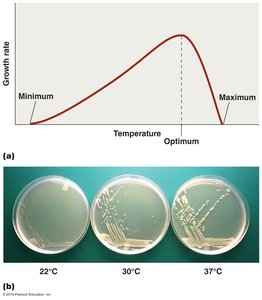
Graph showing the effect of temperature on microbial growth rate and petri dishes with bacterial growth at different temperatures

BackMicrobial Control: Physical and Chemical Methods, and Factors Affecting Microbial Growth
Study Guide - Smart Notes
Tailored notes based on your materials, expanded with key definitions, examples, and context.
Limits to Microbial Growth and Microbial Control
Key Definitions in Microbial Control
Understanding the terminology of microbial control is essential for distinguishing between different methods and their applications in clinical and laboratory settings.
Sterilization: The complete destruction or removal of all living microbes, including spores and viruses.
Sanitization: The reduction or inhibition of microbial contamination to safe levels, as determined by public health standards.
Disinfection: The killing of pathogenic microbes, typically on inanimate objects.
Disinfectant: Chemical agent used to treat inanimate objects.
Antiseptic: Chemical agent used to treat living tissues.
Bactericidal agent: Kills bacteria.
Bacteriostatic agent: Inhibits bacterial growth without killing.
Virucidal agent: Inactivates viruses.
Fungicidal agent: Kills fungi.
Factors Influencing Microbial Growth
Temperature
Temperature is a critical factor that governs microbial growth. Each microorganism has a minimum, optimum, and maximum temperature for growth. The optimum temperature is where growth rate is highest.
Psychrophiles: Grow best at cold temperatures (0–20°C).
Psychrotrophs: Grow at low temperatures but have a higher optimum than psychrophiles.
Mesophiles: Grow best at moderate temperatures (20–45°C), including most human pathogens.
Thermophiles: Grow best at high temperatures (45–80°C).
Hyperthermophiles: Grow at extremely high temperatures (above 80°C).

Applications and Examples
Human pathogens are typically mesophiles, thriving at body temperature (37°C).
Food spoilage in refrigerators is often due to psychrotrophs.
Physical Methods of Microbial Control: Heat
Heat is one of the most effective physical methods for controlling microbial growth. It can be applied as moist or dry heat.
Autoclaving: Uses moist heat under pressure (121.5°C, 15 psi, 15 min) to sterilize materials. Effective for most items except heat-sensitive substances.
Dry Heat: Includes hot-air ovens and incineration. Used for materials that can withstand high temperatures.
Pasteurization: Reduces microbial load in food and beverages, targeting pathogens like Salmonella and E. coli. Methods include holding (63°C for 30 min), flash (71.6°C for 15 sec), and ultra-high temperature (140°C for 3 sec).



Oxygen Requirements
Oxygen availability affects microbial growth, with different bacteria exhibiting distinct oxygen requirements.
Obligate aerobes: Require oxygen for growth.
Obligate anaerobes: Cannot tolerate oxygen.
Facultative anaerobes: Can grow with or without oxygen, but grow better with it.
Microaerophiles: Require low levels of oxygen.
Aerotolerant anaerobes: Do not use oxygen but tolerate its presence.


Oxygen Toxicity and Enzymatic Defense
Singlet oxygen (1O2): Highly reactive, can damage cellular components.
Superoxide (O2-): Detoxified by superoxide dismutase (SOD):
Peroxide anion (O22-): Detoxified by catalase:
pH
Microorganisms have specific pH ranges for optimal growth. Most bacteria prefer neutral pH (around 7), but some can tolerate or thrive in acidic or basic environments.
Acidophiles: Grow at low pH (acidic conditions), e.g., Lactobacillus in yogurt.
Neutrophiles: Grow best at neutral pH.
Alkaliphiles: Grow at high pH (basic conditions).

Salt Tolerance (Osmotic Pressure)
Salt concentration affects microbial growth by influencing osmotic pressure. Organisms are classified based on their salt tolerance:
Halophiles: Require high salt concentrations for growth.
Halotolerant: Can tolerate some salt but grow best without it.
Nonhalophiles: Grow best in low-salt environments.

Osmotic Effects
Hypertonic environments: Cause water to leave the cell, leading to plasmolysis (cell shrinkage).
Isotonic environments: No net movement of water.
Hypotonic environments: Water enters the cell, which may cause lysis.


Food Preservation
Pickling uses high salt and acidic conditions to inhibit microbial growth, except for halophiles and acidophiles.

Radiation
Radiation is used to control microbial growth by damaging DNA and other cellular components.
Ultraviolet (UV) light: Causes thymine dimers in DNA, inhibiting replication and transcription.
Ionizing radiation (X-rays, gamma rays): Produces free radicals that disrupt cellular processes.

Filtration
Filtration is used to remove microbes from heat-sensitive liquids and air. High-efficiency particulate air (HEPA) filters are used in clinical and laboratory settings to maintain sterile environments.

Chemical Methods of Microbial Control
Disinfectants and Antiseptics
Chemical agents are used to control microbial growth on surfaces, instruments, and living tissues. Their effectiveness depends on concentration, exposure time, and the presence of organic matter.
Phenol and derivatives: Disrupt cell membranes and denature proteins. Phenol coefficient is used to compare effectiveness.
Halogens (chlorine, iodine): Oxidize proteins and inactivate enzymes. Used in water treatment and antiseptics.
Heavy metals (silver, mercury, copper): Interfere with microbial metabolism by binding to proteins.
Surfactants (soaps, detergents): Reduce surface tension, aiding in mechanical removal of microbes.
Alcohols (ethanol, isopropanol): Denature proteins and disrupt membranes. Effective at 60–90% concentrations.
Hydrogen peroxide: Damages cellular components via reactive oxygen species.
Aldehydes (formaldehyde, glutaraldehyde): Cross-link proteins and nucleic acids, used for sterilization of instruments.
Gaseous agents (ethylene oxide): React with proteins and nucleic acids, used for heat-sensitive materials.
Chemotherapy and Antimicrobial Drugs
Principle of Selective Toxicity
Selective toxicity refers to the ability of a drug to target microbial cells without harming host cells. This principle is fundamental in the development of antibiotics and chemotherapeutic agents.
Seminal Figures in Antimicrobial Development
Paul Ehrlich: Developed Salvarsan, the first chemotherapeutic agent against Treponema pallidum.
Alexander Fleming: Discovered penicillin, the first true antibiotic.
Gerhard Domagk: Developed prontosil, leading to sulfa drugs.
Mechanisms of Action of Antimicrobials
Cell wall synthesis inhibitors: Penicillins, cephalosporins, vancomycin, bacitracin, isoniazid, ethambutol.
Protein synthesis inhibitors: Aminoglycosides, tetracyclines, chloramphenicol.
Nucleic acid synthesis inhibitors: Quinolones, nucleoside analogs.
Metabolic pathway inhibitors: Sulfonamides, trimethoprim.
Cell membrane disruptors: Polymyxins, daptomycin.
Antibiotic Resistance
Resistance can develop through mutations or acquisition of resistance genes. Mechanisms include enzymatic degradation, altered targets, efflux pumps, and biofilm formation. The Kirby-Bauer disk diffusion test is used to assess susceptibility.
Summary Table: Physical Methods of Microbial Control
Method | Conditions | Action | Representative Uses |
|---|---|---|---|
Boiling | 10 min at 100°C | Denatures proteins, destroys membranes | Disinfection of liquids, baby bottles |
Autoclaving | 15 min at 121°C | Denatures proteins, destroys membranes | Sterilization of media, instruments |
Pasteurization | 15 sec at 72°C | Denatures proteins, destroys membranes | Milk, juices |
Ultra-high-temp | 1–3 sec at 140°C | Denatures proteins, destroys membranes | Sterilization of dairy products |
Filtration | Filter pore size varies | Physically separates microbes | Heat-sensitive liquids, air |
Ionizing radiation | Seconds to hours | Destroys DNA | Medical supplies, food |
UV radiation | Seconds to minutes | Forms thymine dimers in DNA | Surface disinfection |
Additional info: This guide integrates foundational concepts from microbial control, including physical and chemical methods, and the environmental factors that influence microbial growth. It is suitable for exam preparation in a college-level microbiology course.